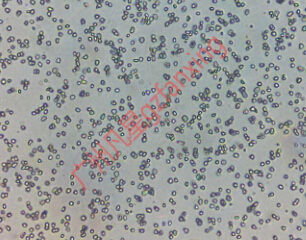

廣州凡星超硬材料有限公司
18820095976W40金剛石微粉500目M30-40
2014-12-21 | 1080

- 分類:超硬材料>金剛石微粉
- 供應商:廣州凡星
- 規格:W40
- 磨削精度:高
- 價格:面議
- 單位:克拉
- 供應數量:大量供應
- 最小起訂量:1000
- 供應地:廣東省>廣州市>白云區
- 用途:適用于玻璃、陶瓷、硬質合金、天然鉆石、寶石等高硬度材料
- 有效期:長期有效
- 立即詢盤
詳情說明
舊國標型號:W40
新國標型號:M30/40
目數:500目
公稱尺寸中值D50(μm):35.0±3.0
本公司的高端金剛石微粉采用高強度、高純度的優質金剛石,運用國際最先進生產工藝,保證了金剛石微粉的純度,使金剛石顆粒具有晶形規則、粒度分布集中、雜質微量、熱穩定性好、耐磨性能高特點;嚴格的分選工藝保證了顆粒的高比例和顆粒名義尺寸相一致,只允許很小的偏差,完全達到并超過國家標準。
用途:我公司高端產品可用于光學玻璃、半導體、精密拋光片、精密砂輪、精細陶瓷、寶石玉器精密加工工具等產品的研磨拋光和金剛石研磨膏、拋光劑的生產;普通產品可用于金屬結合劑磨具、陶瓷結合劑磨具,樹脂結合劑磨具、各類電鍍工具、研磨膏、研磨液等。
包裝:5000ct 10000ct可按客戶需要包裝
產地:國產
Diamond powder







